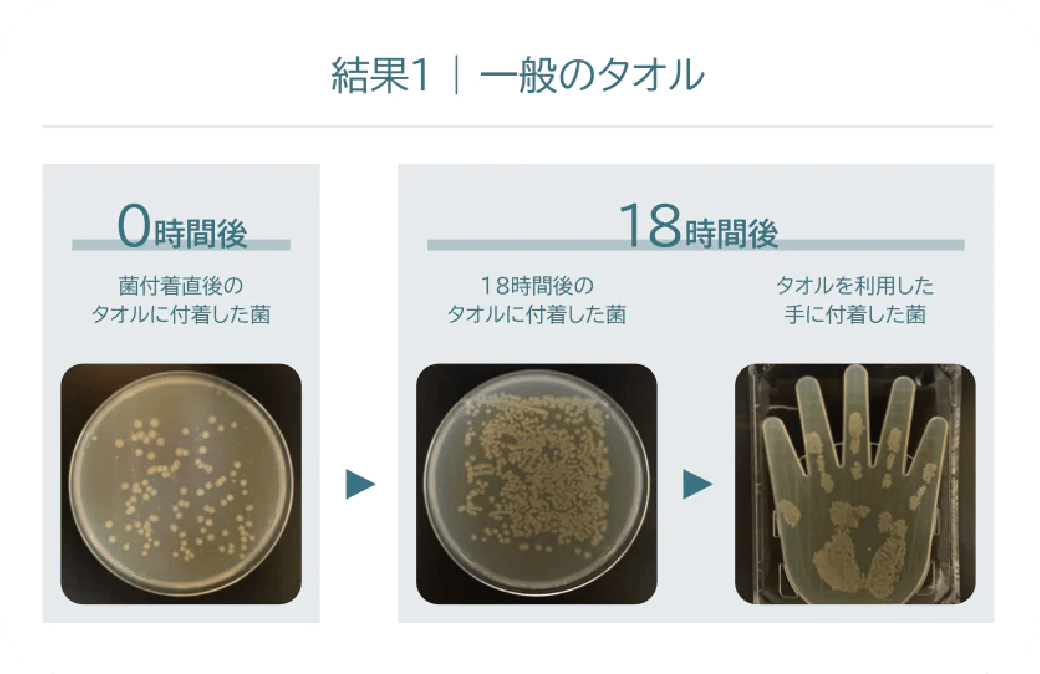
⼀般的なタオル
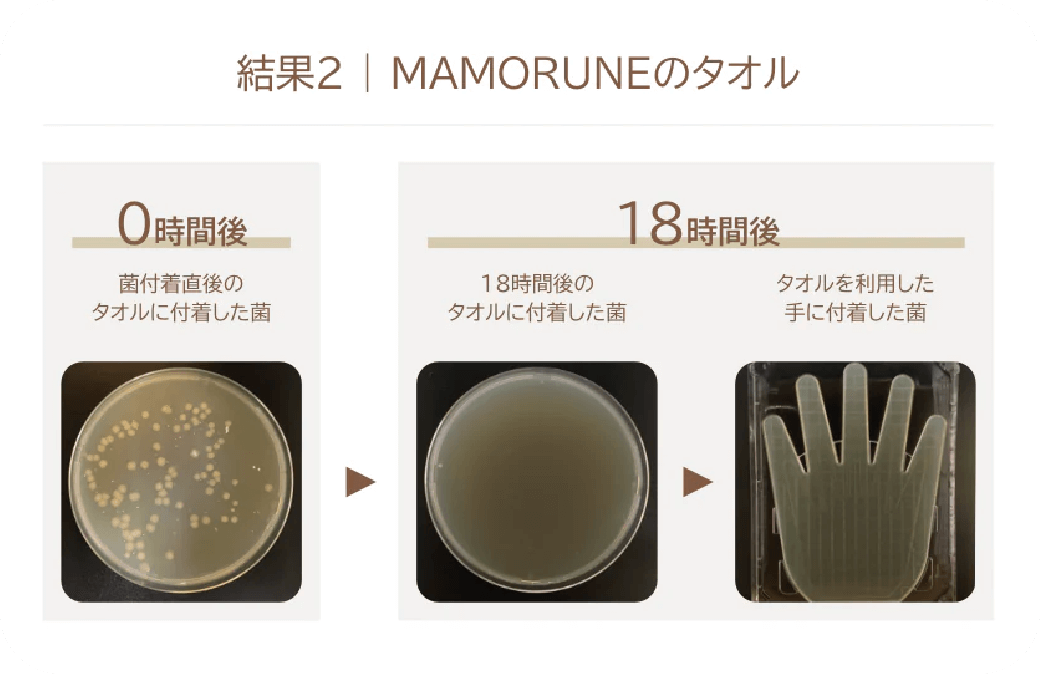
MAMORUNEのタオル

⼀度でも
⼿を洗ったタオルは、
菌だらけでした。
⼀般的なタオルは、⼀度でも⼿や顔を拭くと、⼿や顔に付いていた菌がタオルに移り知らない間に増殖し続けてしまいます。
MAMORUNEは、優れた抗菌効果で菌の増殖を防ぐ、安⼼して使える本当に清潔なタオルです。
⼀般的なタオルは、使⽤から18時間が経つと菌が何倍にも増えてしまいます。その菌は、タオルを使⽤した⼈の⼿や顔に移っていきます。
MAMORUNEのタオルは、使⽤から18時間後にはほとんどの菌が残っていません。安⼼して使⽤いただける抗菌性があります。
<検査実施機関>
一般財団法人日本繊維製品品質技術センター 神戸試験センター報告書No.22KB-070264にて実施。

※⼀般財団法⼈⽇本繊維製品品質技術センター 神⼾試験センターによる検査
200回洗っても
抗菌機能が続き、
⽣乾き臭も防ぎます。
⼀般的なタオルの抗菌効果は、洗濯を繰り返すとその機能が失われてしまいます。MAMORUNEは、洗濯を200回⾏ったあとでも抗菌効果が失われず、菌の増殖を抑え続けることが検査によって実証されています。清潔で⽣乾き臭も防ぐ、ずっと気持ちよく使っていただけるタオルです。

やわらかくて、しっかり吸⽔。
使い⼼地も最⾼品質です。
⼿や顔を拭くたびにうれしくなる。そんな最⾼の⼼地良さを⽬指して開発しました。MAMORUNEは、50年以上にわたってタオル作りに携わってきた経験と技術を活かし、コストを抑えながらも最上級の使い⼼地を叶えたタオルです。









ラインアップ

マモルネの各シリーズは、糸の太さや撚り
(複数の糸をねじり合わせること)の強さなどがちがい、
それぞれに特長があります。
-
しっかり拭けて心地いい

やわらかさ

 タオルの糸としては標準的な太さと撚りの強さ。しっかりと拭けて水をよく吸い、快適な肌触り。バランスの取れた誰からも好まれるタオルです。
タオルの糸としては標準的な太さと撚りの強さ。しっかりと拭けて水をよく吸い、快適な肌触り。バランスの取れた誰からも好まれるタオルです。 -
とろける至福の肌触り

やわらかさ

 産毛のように繊細な糸を、大胆に甘く撚って。クリームのようにとろりとした夢見心地の肌触り。甘撚りの難点、毛羽落ちへの対策を施しています。
産毛のように繊細な糸を、大胆に甘く撚って。クリームのようにとろりとした夢見心地の肌触り。甘撚りの難点、毛羽落ちへの対策を施しています。 -
これまでにない爽快感

やわらかさ

 太さがちがう2本の糸を撚り合わせた特別な糸を使用。パイルが倒れにくく、タオルと肌が、面ではなく点で接することで、さっぱり爽快な新感覚の拭き心地が生まれました。身体を拭くのが楽しみになる1枚です。
太さがちがう2本の糸を撚り合わせた特別な糸を使用。パイルが倒れにくく、タオルと肌が、面ではなく点で接することで、さっぱり爽快な新感覚の拭き心地が生まれました。身体を拭くのが楽しみになる1枚です。




Q&A
- Q
- ⼿ざわりや吸⽔性が
⻑持ちするのはなぜですか?
私たちKBツヅキは、タオルを綿の段階からこだわって作っており、綿本来のやわらかさが⻑く続くタオルを開発しています。通常、綿花は運搬の過程で圧縮されて傷んでしまいますが、私たちはその綿花を20〜40⽇かけてじっくり⽔分を含ませ、もとのみずみずしい状態に戻しています。また、「MFTS⽅式」など独⾃の技術を採⽤することで、⽑⽻落ちしにくく耐久性がありながらもふんわりとした⾵合いが持続するタオルの開発に成功しました。
- Q
- ⽣乾き臭を防ぐ抗菌効果は
どれくらい持続しますか?
検査の結果、少なくとも200回は洗濯をしても抗菌効果が失われないことを実証しています。抗菌機能を持ったタオルは世の中に多くありますが、数回の洗濯で効果が失われてしまうタオルも少なくありません。私たちは第三者機関による検査を⾏い、抗菌効果が持続することを実証しています。
- Q
- ⾚ちゃんや⼩さな⼦どもでも
安⼼して使えるタオルですか?
MAMORUNEは、⾚ちゃんをはじめ、どなたでも安⼼して使っていただけるよう有害物質の残留試験をしています。当社独⾃の試験により、ホルムアルデヒドや残留農薬など350もの有害物質の残留試験をクリアしました。やわらかな⼿ざわり、優れた抗菌機能もありますので、安⼼して⻑く使っていただくことができます。
- Q
- なぜ⾼機能なタオルを安価に
作ることができるのですか?
私たちKBツヅキは、50年以上にわたってタオル作りに携わってきた紡績メーカーです。タオルの原材料である綿を仕⼊れて⾃分たちで⽷を作っており、綿⽷の⽣産量では⽇本⼀。今治タオル向けの綿⽷出荷量も国内最多となっております。
MAMORUNEは、そんなタオル作りの裏⽅であった私たちが、これまでの技術を集結して開発をしました。優れた機能を持たせながらも、⾃社製造による無駄のないものづくりでコストを抑え、できるだけお求めやすい価格帯になるように努⼒をしています。












